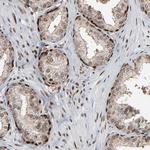
MEIS2 Antibody in Immunohistochemistry (Paraffin) (IHC (P))

Search
Invitrogen
MEIS2 Polyclonal Antibody
{{$productOrderCtrl.translations['antibody.pdp.commerceCard.promotion.promotions']}}
{{$productOrderCtrl.translations['antibody.pdp.commerceCard.promotion.viewpromo']}}
{{$productOrderCtrl.translations['antibody.pdp.commerceCard.promotion.promocode']}}: {{promo.promoCode}} {{promo.promoTitle}} {{promo.promoDescription}}. {{$productOrderCtrl.translations['antibody.pdp.commerceCard.promotion.learnmore']}}
产品信息
PA5-82072
种属反应
宿主/亚型
分类
类型
抗原
偶联物
形式
浓度
规格
纯化类型
保存液
内含物
保存条件
运输条件
RRID
产品详细信息
Immunogen sequence: LEKVHELCDN FCHRYISCLK GKMPIDLVID ERDGSSKSDH EELSGSSTNL ADHNPSSWRD HDDATSTHSA GTPGPSSGGH ASQSGDNSSE QGDGLDNSV
Highest antigen sequence indentity to the following orthologs: Rat - 100%, Mouse - 100%.
靶标信息
This gene encodes a homeobox protein belonging to the TALE family of homeodomain-containing proteins. TALE homeobox proteins are highly conserved transcription regulators, and several members have been shown to be essential contributors to developmental programs. Multiple transcript variants encoding distinct isoforms have been described for this gene.
仅用于科研。不用于诊断过程。未经明确授权不得转售。
篇参考文献 (0)
生物信息学
蛋白别名: Homeobox protein Meis2; Meis homolog 2; Meis1, myeloid ecotropic viral integration site 1 homolog 2; Meis1-related gene 1; Meis1-related protein 1; MGC2820; OTTHUMP00000160209; TALE homeobox protein Meis2; unnamed protein product
基因别名: CPCMR; HsT18361; MEIS2; MRG1
UniProt ID: (Human) O14770
Entrez Gene ID: (Human) 4212